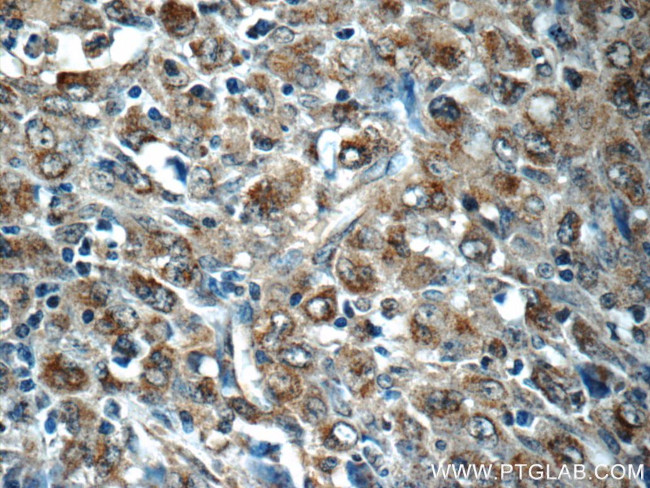
PDP2 Antibody in Immunohistochemistry (Paraffin) (IHC (P))

Search
Proteintech
PDP2 Polyclonal Antibody
{{$productOrderCtrl.translations['antibody.pdp.commerceCard.promotion.promotions']}}
{{$productOrderCtrl.translations['antibody.pdp.commerceCard.promotion.viewpromo']}}
{{$productOrderCtrl.translations['antibody.pdp.commerceCard.promotion.promocode']}}: {{promo.promoCode}} {{promo.promoTitle}} {{promo.promoDescription}}. {{$productOrderCtrl.translations['antibody.pdp.commerceCard.promotion.learnmore']}}
产品信息
13404-1-AP
已发表种属
宿主/亚型
分类
类型
抗原
偶联物
形式
浓度
保存条件
运输条件
产品详细信息
Immunogen sequence: LHVANAGDC RAILGVQEDN GMWSCLPLTR DHNAWNQAEL SRLKREHPES EDRTIIMEDR LLGVLIPCRA FGDVQLKWSK ELQRSILERG FNTEALNIYQ FTPPHYYTPP YLTAEPEVTY HRLRPQDKFL VLASDGLWDM LSNEDVVRLV VGHLAEADWH KTDLAQRPAN LGLMQSLLLQ RKASGLHEAD QNAATRLIRH AIGNNEYGEM EAERLAAMLT LPEDLARMYR DDITVTVVYF NSESIGAYYK (279-527 aa encoded by BC028030)
靶标信息
Catalyzes the dephosphorylation and concomitant reactivation of the alpha subunit of the E1 component of the pyruvate dehydrogenase complex.
仅用于科研。不用于诊断过程。未经明确授权不得转售。